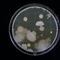
¿Bacteria carnívora de Japón mata al humano en 2 días? Esto sabemos del shock tóxico estreptocócico

China descubrió una bacteria mutante en su Estación Espacial que sobrevive en condiciones extremas.
La comunidad científica se encuentra sorprendida por localizar una bacteria en la Estación Espacial Tiangong.
La bacteria mutante que China encontró en su Estación Espacial
Se reveló que en la Estación Espacial China (CSS) se halló una bacteria mutante muy resistente.

De acuerdo con los expertos, se trata de la cepa Niallia tiangongensis, que sería una variante inédita del género Niallia de la familia Cytobacillaceae.

La bacteria se detectó en la superficie de un equipo que estaba instalado en el módulo de la Estación Espacial.
Y fue confirmada por un estudio publicado en la revista International Journal of Systematic and Evolutionary Microbiology.
La investigación sobre la bacteria la realizaron el:
- Grupo de Biotecnología Espacial de Shenzhou
- Instituto de Ingeniería de Sistemas Espaciales de Pekín
Cabe mencionar que el descubrimiento se logró por el Programa del Microbioma del Área Habitable de la CSS.
Dicho programa tiene la meta de indagar sobre el entorno microbiano que hay en el laboratorio espacial de la Estación Espacial Tiangong.
Su importancia permite cuestionar los protocolos actuales de desinfección y aislamiento de bacterias que tienen las misiones especiales.

Bacteria mutante en Estación Espacial China sobrevive a condiciones extremas
La tripulación de misión Shenzhou-15 de China tomó muestras de la bacteria con hisopos para estudiarse en la Tierra con:
- Técnicas de imagenología de alta resolución
- Estudios filogenéticos comparativos
También, gracias al análisis genómico que realizaron científicos de la bacteria mutante, se logró conocer más sobre ella.
Se determinó que es una súper bacteria, que se encuentra muy bien adaptada a la vida que existe en el espacio exterior.
Los datos ayudaron a comprender que a nivel morfológico, es similar a otras del género Niallia.
No obstante, la bacteria destaca entre las demás porque tiene alta resistencia a la radiación.
Además de que cuenta con la capacidad de formar esporas igualmente fuertes.
Y también crear capas de biofilm; es decir, microrganismos que se adhieren a una superficie, los cuales funcionan como protección en entornos negativos.
A esas características de la bacteria se debe sumar que el microorganismo descompone elementos con la intención de conseguir:
- Nitrógeno
- Carbono
Con el descubrimiento de la bacteria mutante en China, los expertos indican que su hallazgo permitirá generar nuevos estudios.
Principalmente, sobre la adaptación de microorganismos en lo que son entornos cerrados.
Esto servirá de igual manera para los viajes espaciales y la seguridad de los astronautas en expediciones que duren mucho tiempo.

